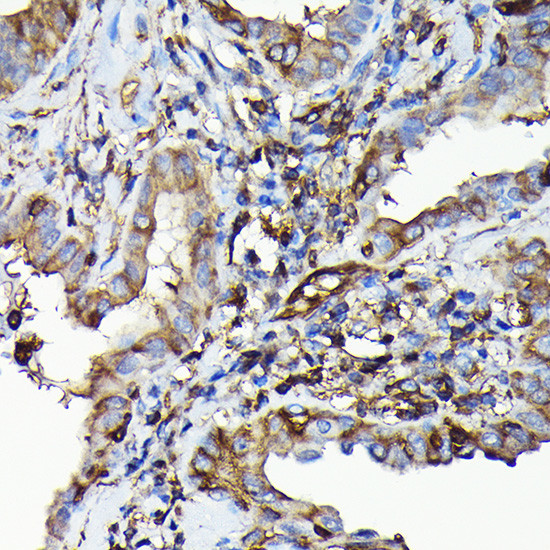
MYH9 Antibody in Immunohistochemistry (Paraffin) (IHC (P))

Search
Invitrogen
MYH9 Polyclonal Antibody
{{$productOrderCtrl.translations['antibody.pdp.commerceCard.promotion.promotions']}}
{{$productOrderCtrl.translations['antibody.pdp.commerceCard.promotion.viewpromo']}}
{{$productOrderCtrl.translations['antibody.pdp.commerceCard.promotion.promocode']}}: {{promo.promoCode}} {{promo.promoTitle}} {{promo.promoDescription}}. {{$productOrderCtrl.translations['antibody.pdp.commerceCard.promotion.learnmore']}}
图: 1 / 4
MYH9 Antibody (PA5-120506) in IHC (P)




Please note: We are reviewing Western blot images included in the antibody testing data in our catalog, including those provided by third parties. Unless expressly labeled or annotated as “raw-unedited”, Western blot images included in the antibody testing data in our catalog may have been edited, optimized or otherwise adjusted for presentation.
产品信息
PA5-120506
种属反应
宿主/亚型
分类
类型
抗原
偶联物
形式
浓度
规格
纯化类型
保存液
内含物
保存条件
运输条件
RRID
产品详细信息
Positive test controls include: HeLa, HT-29, A-549, NIH/3T3, C6. The target is usually found in the following locations: Cytoplasm, cell cortex, cytoskeleton.
Immunogen sequence: VKSKYKASIT ALEAKIAQLE EQLDNETKER QAACKQVRRT EKKLKDVLLQ VDDERRNAEQ YKDQADKAST RLKQLKRQLE EAEEEAQRAN ASRRKLQREL EDATETADAM NREVSSLKNK LRRGDLPFVV PRRMARKGAG DGSDEEVDGK ADGAEAKPAE
靶标信息
The MYH9 gene, located on chromosome 22q12.3, encodes the heavy chain of non-muscle myosin IIA (NMHC IIA), a critical component of the actin cytoskeleton that plays essential roles in various cellular processes. Structurally, the MYH9 gene spans over 106 kilobases and includes 41 exons that translate into a protein of 1,960 amino acids. This protein is a part of a hexameric complex, which includes two heavy chains, two regulatory light chains, and two essential light chains. The NMHC IIA protein interacts with actin filaments and is involved in cellular activities such as cell migration, adhesion, division, and maintenance of cell shape. Functionally, mutations in MYH9 can result in a spectrum of autosomal dominant disorders collectively known as MYH9-related diseases (MYH9-RD), which include conditions such as May-Hegglin anomaly, Fechtner syndrome, and Epstein syndrome. These disorders are primarily characterized by macrothrombocytopenia (abnormally large platelets) and may lead to other complications such as hearing loss, renal failure, and cataracts later in life. MYH9 is also crucial in hematopoiesis, where its proper function is necessary for the survival and maintenance of hematopoietic stem and progenitor cells (HSPCs). Loss of MYH9 function disrupts normal hematopoiesis, leading to severe blood cell deficiencies and bone marrow failure.
仅用于科研。不用于诊断过程。未经明确授权不得转售。
篇参考文献 (0)
生物信息学
蛋白别名: Cellular myosin heavy chain, type A; flectin; MGC104539; Myosin heavy chain 9; myosin heavy chain IX; Myosin heavy chain, non-muscle IIa; myosin IIA; Myosin-9; myosin-9-like; myosin9; NMHC II-A; NMHC-II A; NMMHC II-a; NMMHC IIA; NMMHC-A; Non-muscle myosin heavy chain A; Non-muscle myosin heavy chain IIa
基因别名: Fltn; MYH9; Myhn-1; Myhn1; NMHCIIA; NMMHC-A; NMMHC-IIA; TU72.6
UniProt ID: (Mouse) Q8VDD5
Entrez Gene ID: (Rat) 100911597, (Mouse) 17886